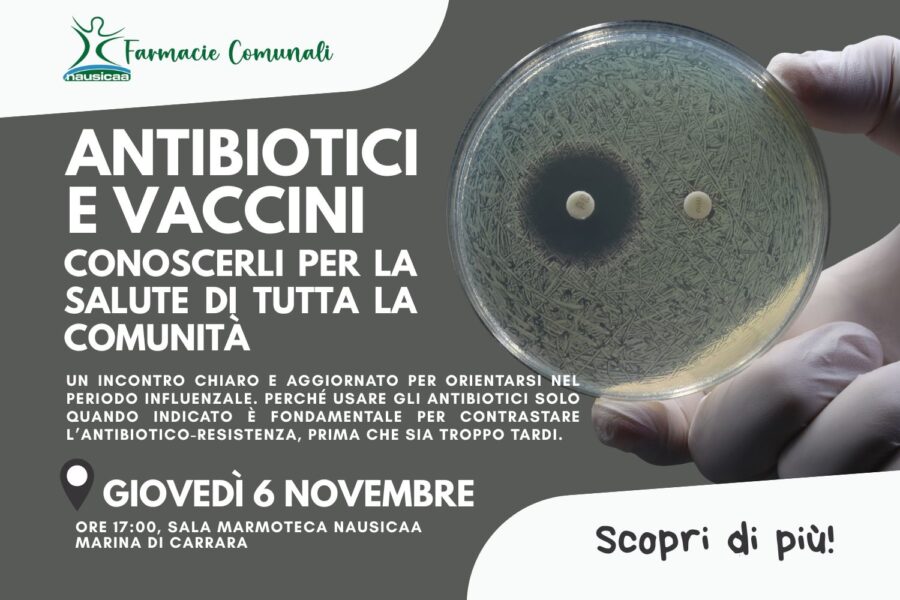
antibiotici-vaccini-convegno-6-novembre-nausicaa

Nausicaa Carrara
Una sola azienda,
tanti servizi per il cittadino
Nella nuova sede aziendale, in viale Galilei 133 a Marina di Carrara, lavoriamo ogni giorno per garantire puntualmente i 10 servizi in house del Comune di Carrara e per creare una rete sempre più virtuosa tra le realtà del territorio. Per il benessere di tutta la comunità.
La rinnovata Sala Marmoteca, una sala conferenze da 200 posti, ospita eventi di formazione gratuita e informazione per tutta la cittadinanza, organizzati da Nausicaa in collaborazione con enti istituzionali e associativi della città e oltre.
Le nostre 7 farmacie comunali ospitano continuamente attività gratuite e innovative di screening assieme ad ASL Toscana Nord Ovest, ad integrazione del Sistema Sanitario Nazionale e dedicate a tutta la comunità.

Aggiornamenti
Ultime notizie da Nausicaa Carrara
- Informarsi per proteggersi: a San Valentino a Nausicaa si parla di affettività e salute sessuale
 Carrara, 10/02/2026 – Nausicaa SpA, in collaborazione con i medici di famiglia del territorio, ha promosso a San Valentino un convegno aperto alla cittadinanza dedicato…
Carrara, 10/02/2026 – Nausicaa SpA, in collaborazione con i medici di famiglia del territorio, ha promosso a San Valentino un convegno aperto alla cittadinanza dedicato… - Le farmacie comunali Nausicaa aderiscono allo screening gratuito del tumore del colon retto
 Le farmacie comunali Nausicaa partecipano all’iniziativa promossa da ISPRO e Regione Toscana per lo screening gratuito del tumore del colon retto, rivolto a uomini e donne tra i 50 e i 69 anni.
Le farmacie comunali Nausicaa partecipano all’iniziativa promossa da ISPRO e Regione Toscana per lo screening gratuito del tumore del colon retto, rivolto a uomini e donne tra i 50 e i 69 anni. - Nausicaa SpA rafforza il suo impegno per la salute pubblica nel 2026: i prossimi eventi gratuiti
 Carrara, 09/01/2026 – Nausicaa SpA rilancia il suo impegno per la salute pubblica con un calendario del primo bimestre 2026 ricco di iniziative gratuite rivolte…
Carrara, 09/01/2026 – Nausicaa SpA rilancia il suo impegno per la salute pubblica con un calendario del primo bimestre 2026 ricco di iniziative gratuite rivolte… - Apertura straordinaria cimitero di Turigliano nella giornata di lunedi’ 22 dicembre 2025
 Si COMUNICA che in via del tutto eccezionale, l’apertura al pubblico del cimitero di Turigliano nella giornata di lunedì 22 dicembre 2025, dalle ore 08.00…
Si COMUNICA che in via del tutto eccezionale, l’apertura al pubblico del cimitero di Turigliano nella giornata di lunedì 22 dicembre 2025, dalle ore 08.00… - Un rinnovato spazio di svago per giovani e famiglie: l’inaugurazione del nuovo parco giochi di Nazzano
 Mercoledì 19 novembre, il quartiere di Nazzano ha vissuto un momento di festa e condivisione in occasione dell’inaugurazione del nuovo parco giochi e del campo…
Mercoledì 19 novembre, il quartiere di Nazzano ha vissuto un momento di festa e condivisione in occasione dell’inaugurazione del nuovo parco giochi e del campo… - Antibiotici e vaccini, a Nausicaa un incontro per cittadini: “conoscerli per la salute di tutta la comunità”
La stagione più fredda porta con sé un aumento della circolazione di influenza e COVID.Per aiutare i cittadini a orientarsi tra prevenzione, resistenza microbica e…
La stagione più fredda porta con sé un aumento della circolazione di influenza e COVID.Per aiutare i cittadini a orientarsi tra prevenzione, resistenza microbica e…

SALE MEETING
Nausicaa organizza presso la sua sede numerosi incontri pubblici a carattere informativo e formativo

